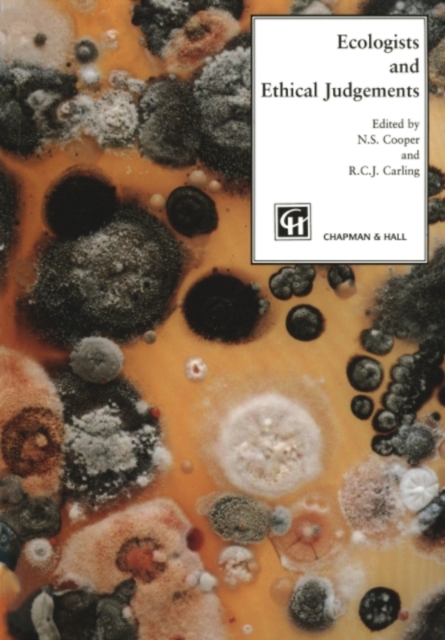
Ecologists and Ethical Judgements

Ecologists and Ethical Judgements
Available
How we see the world - our attitudes and assumptions about it - profoundly affects the way we deal with it. This book is written by an interdisciplinary team of ecologists, nature conservationists and environmental philosophers. It seeks to make the connection between the theoretical approaches to the valuation of the natural world and how these work in practice.
E-book
pdf
Price
89.50 £
How we see the world - our attitudes and assumptions about it - profoundly affects the way we deal with it. This book is written by an interdisciplinary team of ecologists, nature conservationists and environmental philosophers. It seeks to make the connection between the theoretical approaches to the valuation of the natural world and how these work in practice.